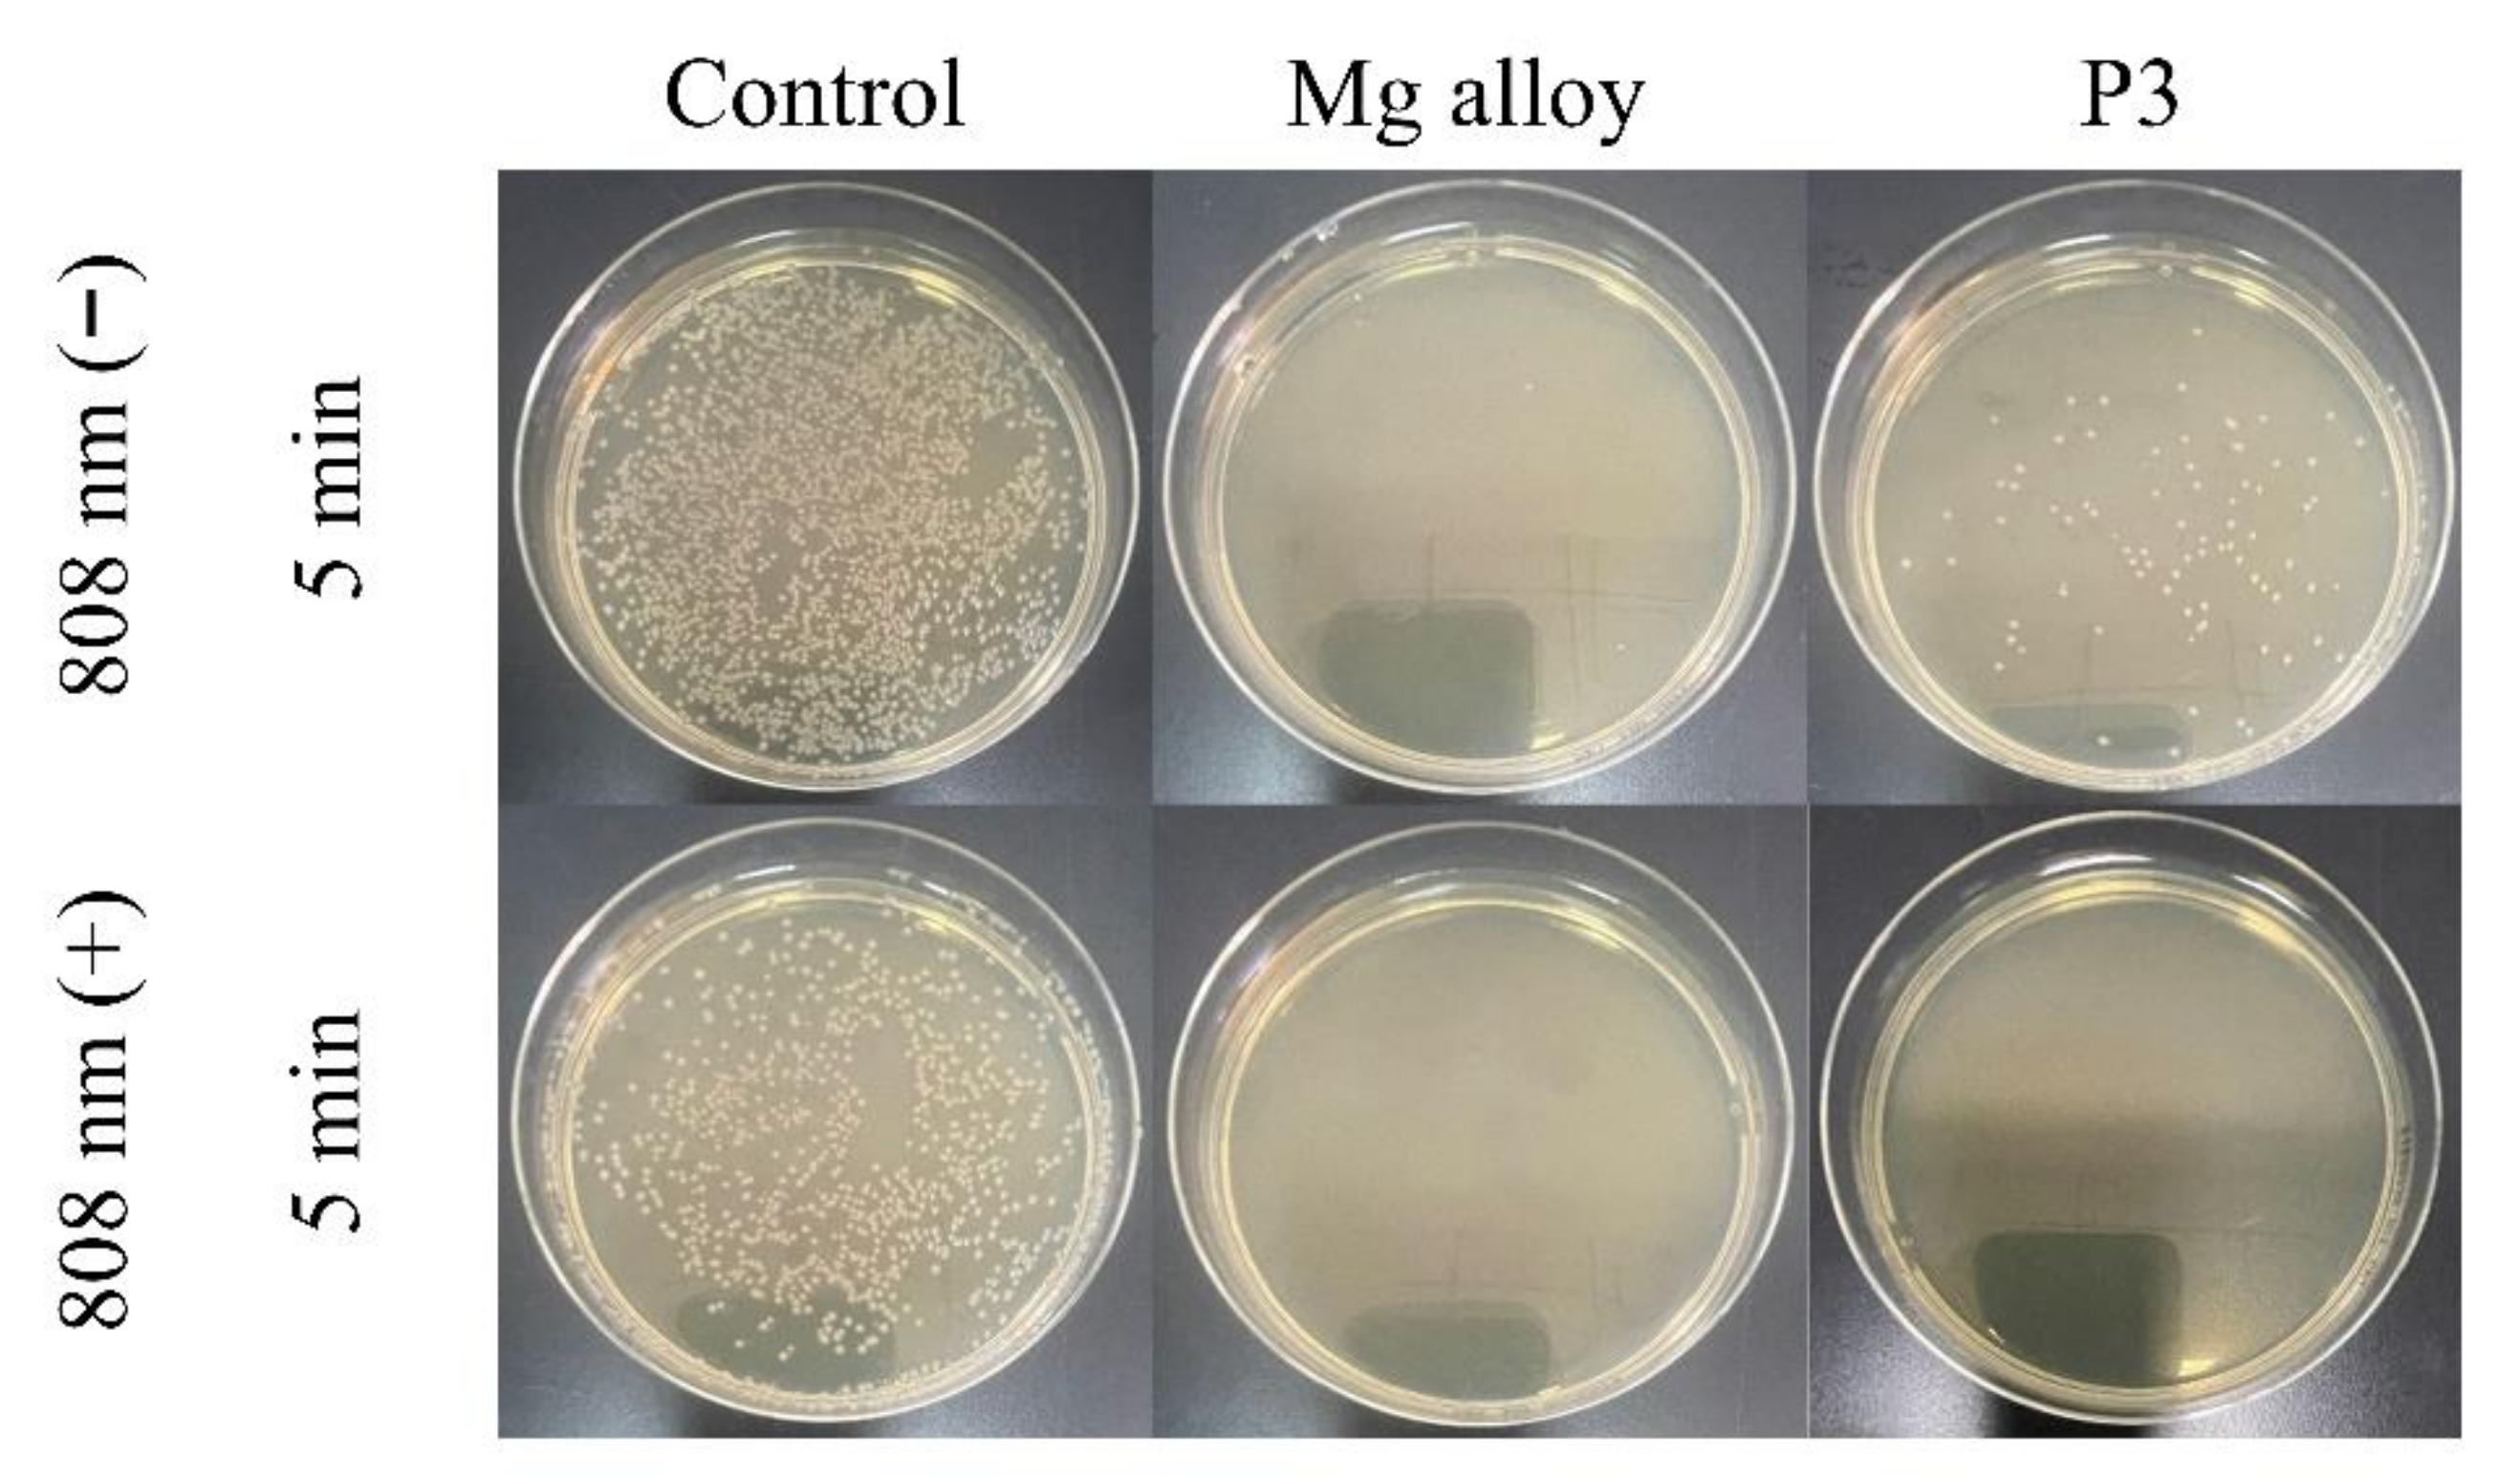
Ijms 23 10708 g012 550

Study on Enhancing the Corrosion Resistance and Photo-Thermal Antibacterial Properties of the Micro-Arc Oxidation Coating Fabricated on Medical Magnesium Alloy
Abstract
:1. Introduction
2. Result
2.1. Composition and Surface Morphology of Coated Samples
2.2. Corrosion Resistance of the MAO Coating
2.3. Photo-Thermal Effect and Mechanism of MAO Coatings with Different Current Densities
2.4. The Antibacterial Mechanism of the MAO Coating
3. Materials and Methods
3.1. Materials and MAO Coatings Preparation
3.2. Characterization of the Coatings
3.3. Photo-Thermal Property Measurement
3.4. Corrosion Characterization
3.5. In Vitro Antibacterial Test
4. Conclusions
Author Contributions
Funding
Institutional Review Board Statement
Informed Consent Statement
Data Availability Statement
Conflicts of Interest
References
- Kopp, A.; Smeets, R.; Jung, O.; Kröger, N.; Klink, A. Defined surface adjustment for medical magnesium implants by electrical discharge machining (EDM) and plasma electrolytic oxidation (PEO). CIRP Ann. 2019, 68, 583–586. [Google Scholar] [CrossRef]
- Yang, Q.; Yuan, W.; Liu, X.; Zheng, Y.; Cui, Z.; Yang, X.; Pan, H.; Wu, S. Atomic layer deposited ZrO2 nanofilm on Mg-Sr alloy for enhanced corrosion resistance and biocompatibility. Acta Biomater. 2017, 58, 515–526. [Google Scholar] [CrossRef] [PubMed]
- Carangelo, A.; Acquesta, A.; Monetta, T. In-vitro corrosion of AZ31 magnesium alloys by using a polydopamine coating. Bioact. Mater. 2019, 4, 71–78. [Google Scholar] [CrossRef] [PubMed]
- Schierholz, J.M.; Beuth, J. Implant infections: A haven for opportunistic bacteria. J. Hosp. Infect. 2001, 49, 87–93. [Google Scholar] [CrossRef] [PubMed]
- Wang, B.-L.; Liu, X.-S.; Ji, Y.; Ren, K.-F.; Ji, J. Fast and long-acting antibacterial properties of chitosan-Ag/polyvinylpyrrolidone nanocomposite films. Carbohydr. Polym. 2012, 90, 8–15. [Google Scholar] [CrossRef] [PubMed]
- Rajabi, S.K.; Sohrabnezhad, S.; Ghafourian, S. Fabrication of Fe3O4@CuO core-shell from MOF based materials and its antibacterial activity. J. Solid State Chem. 2016, 244, 160–163. [Google Scholar] [CrossRef]
- Guo, Y.-F.; Fang, W.-J.; Fu, J.-R.; Wu, Y.; Zheng, J.; Gao, G.-Q.; Chen, C.; Yan, R.-W.; Huang, S.-G.; Wang, C.-C. Facile synthesis of Ag@ZIF-8 core-shell heterostructure nanowires for improved antibacterial activities. Appl. Surf. Sci. 2018, 435, 149–155. [Google Scholar] [CrossRef]
- Rizwan, M.; Alias, R.; Zaidi, U.Z.; Mahmoodian, R.; Hamdi, M. Surface modification of valve metals using plasma electrolytic oxidation for antibacterial applications: A review. J. Biomed. Mater. Res. A 2018, 106, 590–605. [Google Scholar] [CrossRef]
- Yazici, M.; Gulec, A.E.; Gurbuz, M.; Gencer, Y.; Tarakci, M. Biodegradability and Antibacterial Properties of MAO Coatings formed on Mg-Sr-Ca Alloys in an Electrolyte Containing Ag Doped Hydroxyapatite. Thin Solid Films 2017, 644, 92–98. [Google Scholar] [CrossRef]
- Zhao, Y.; Chen, Y.; Wang, W.; Zhou, Z.; Shi, S.; Li, W.; Chen, M.; Li, Z. One-step in situ synthesis of nano silver-hydrotalcite coating for enhanced antibacterial and degradation property of magnesium alloys. Mater. Lett. 2020, 265, 127349. [Google Scholar] [CrossRef]
- Chen, S.; Lu, J.; You, T.; Sun, D. Metal-organic frameworks for improving wound healing. Coord. Chem. Rev. 2021, 439, 213929. [Google Scholar] [CrossRef]
- Han, X.; Zhang, G.; Chai, M.; Zhang, X. Light-assisted therapy for biofilm infected micro-arc oxidation TiO2 coating on bone implants. Biomed. Mater. 2021, 16, 25018. [Google Scholar] [CrossRef]
- Chai, M.; An, M.; Zhang, X. Construction of a TiO2/MoSe2/CHI coating on dental implants for combating Streptococcus mutans infection. Mater. Sci. Eng. C 2021, 129, 112416. [Google Scholar] [CrossRef]
- Zhang, D.; Zhou, J.; Peng, F.; Tan, J.; Zhang, X.; Qian, S.; Quai, Y.; Zhang, Y.; Liu, X. Mg-Fe LDH sealed PEO coating on magnesium for biodegradation control, antibacteria and osteogenesis. J. Mater. Sci. Technol. 2022, 105, 57–67. [Google Scholar] [CrossRef]
- Zhang, D.; Cheng, S.; Tan, J.; Xie, J.; Zhang, Y.; Chen, S.; Du, H.; Qian, S.; Qiao, Y.; Peng, F.; et al. Black Mn-containing layered double hydroxide coated magnesium alloy for osteosarcoma therapy, bacteria killing, and bone regeneration. Bioact. Mater. 2022, 17, 394–405. [Google Scholar] [CrossRef]
- An, W.; Tian, L.; Hu, J.; Liu, L.; Cui, W.; Liang, Y. Efficient degradation of organic pollutants by catalytic ozonation and photocatalysis synergy system using double-functional MgO/g-C3N4 catalyst. Appl. Surf. Sci. 2020, 534, 147518. [Google Scholar] [CrossRef]
- Zheng, X.; Wang, K.; Huang, Z.; Liu, Y.; Wen, J.; Peng, H. MgO nanosheets with N-doped carbon coating for the efficient visible-light photocatalysis. J. Ind. Eng. Chem. 2019, 76, 288–295. [Google Scholar] [CrossRef]
- An, X.; Chen, Y.; Ao, M.; Jin, Y.; Zhan, L.; Yu, B.; Wu, Z.; Jiang, P. Sequential photocatalytic degradation of organophosphorus pesticides and recovery of orthophosphate by biochar/α-Fe2O3/MgO composite: A new enhanced strategy for reducing the impacts of organophosphorus from wastewater. Chem. Eng. J. 2022, 435, 135087. [Google Scholar] [CrossRef]
- Madona, J.; Sridevi, C. Surfactant assisted hydrothermal synthesis of MgO/g-C3N4 heterojunction nanocomposite for enhanced solar photocatalysis and antimicrobial activities. Inorg. Chem. Commun. 2022, 138, 109265. [Google Scholar] [CrossRef]
- Huang, Z.; Zhao, X.; Xia, H.; Lu, F.; Hu, L.; Chu, P.K. Insights into Enhancement of Photocatalytic Properties of g-C3N4 by Local Electric Field Induced by Polarization of MgO(111). J. Environ. Chem. Eng. 2021, 9, 105922. [Google Scholar] [CrossRef]
- Panchal, P.; Paul, D.R.; Gautam, S.; Meena, P.; Nehra, S.P.; Maken, S.; Sharma, A. Photocatalytic and antibacterial activities of green synthesized Ag doped MgO nanocomposites towards environmental sustainability. Chemosphere 2022, 297, 134182. [Google Scholar] [CrossRef]
- Cheng, Y.L.; Feng, T.; Cheng, Y.L. A systematic study of the role of cathodic polarization and new findings on the soft sparking phenomenon from plasma electrolytic oxidation of an Al-Cu-Li alloy. J. Electrochem. Soc. 2022, 163, 071505. [Google Scholar] [CrossRef]
- Shi, X.; Wang, Y.; Li, H.; Zhang, S.; Zhao, R.; Li, G.; Zhang, R.; Sheng, Y.; Cao, S.; Zhao, S.; et al. Corrosion resistance and biocompatibility of calcium-containing coatings developed in near-neutral solutions containing phytic acid and phosphoric acid on AZ31B alloy. J. Alloys Compd. 2020, 823, 153721. [Google Scholar] [CrossRef]
- Zhong, S.; Li, G.; Zhang, S.; Zhao, R.; Jiang, X.; Zhang, R. Preparation and formation mechanism of anodic coatings co-doped with Ga, Si, and P ions on Ti-6Al-4V alloys. Mater. Chem. Phys. 2022, 282, 125923. [Google Scholar] [CrossRef]
- Seyfoori, A.; Mirdamadi, S.; Khavandi, A.; Raufi, Z.S. Biodegradation behavior of micro-arc oxidized AZ31 magnesium alloys formed in two different electrolytes. Appl. Surf. Sci. 2012, 261, 92–100. [Google Scholar] [CrossRef]
- Wu, Y.-K.; Yang, Z.; Wang, R.-Q.; Wu, G.-R.; Chen, D.; Wang, D.-D.; Liu, X.-T.; Li, D.-L.; Guo, C.-H.; Yu, S.-X. An investigation of microstructure evolution for plasma electrolytic oxidation (PEO) coated Al in an alkaline silicate electrolyte. Surf. Coat. Technol. 2018, 351, 136–152. [Google Scholar] [CrossRef]
- Mori, Y.; Koshi, A.; Liao, J.; Asoh, H.; Ono, S. Characteristics and corrosion resistance of plasma electrolytic oxidation coatings on AZ31B Mg alloy formed in phosphate-Silicate mixture electrolytes. Corros. Sci. 2014, 88, 254–262. [Google Scholar] [CrossRef]
- Li, Y.; Wang, W.; Duan, J.; Qi, M. A super-hydrophilic coating with a macro/micro/nano triple hierarchical structure on titanium by two-step micro-arc oxidation treatment for biomedical applications. Surf. Coat. Technol. 2017, 311, 1–9. [Google Scholar] [CrossRef]
- Li, Q.; Liang, J.; Liu, B.; Peng, Z.; Wang, Q. Effects of cathodic voltages on structure and wear resistance of plasma electrolytic oxidation coatings formed on aluminium alloy. Appl. Surf. Sci. 2014, 297, 176–181. [Google Scholar] [CrossRef]
- Li, Z.; Cheng, Y.L.; Kang, S.H.; Tu, W.; Cheng, Y. A re-understanding of the breakdown theory from the study of the plasma electrolytic oxidation of a carbon steel—A non-valve metal. Electrochim. Acta 2018, 284, 681–695. [Google Scholar] [CrossRef]
- Yang, Y.; Liu, Y. Effects of Current Density on the Microstructure and the Corrosion Resistance of Alumina Coatings Embedded with Si C Nano-particles Produced by Micro-arc Oxidation. J. Mater. Sci. Technol. 2010, 26, 1016–1020. [Google Scholar] [CrossRef]
- Cui, L.-Y.; Zeng, R.-C.; Guan, S.-K.; Qi, W.-C.; Zhang, F.; Li, S.-Q.; Han, E.-H. Degradation mechanism of micro-arc oxidation coatings on biodegradable Mg-Ca alloys: The influence of porosity. J. Alloys Compd. 2017, 695, 2464–2476. [Google Scholar] [CrossRef]
- Kalkanci, H.; Kurnaz, S.C. The effect of process parameters on mullite-based plasma electrolytic oxide coatings. Surf. Coat. Technol. 2008, 203, 15–22. [Google Scholar] [CrossRef]
- Gu, Y.; Chen, L.; Yue, W.; Chen, P.; Chen, F.; Ning, C. Corrosion behavior and mechanism of MAO coated Ti6Al4V with a grain-fined surface layer. J. Alloys Compd. 2016, 664, 770–776. [Google Scholar] [CrossRef]
- Wei, Z.L.; Tian, P.; Liu, X.Y.; Zhou, B. In vitro degradation, hemolysis, and cytocompatibility of PEO/PLLA composite coating on biadegradable AZ31 alloy. J. Biomed. Mater. Res. B Appl. Biomater. 2015, 103, 342–354. [Google Scholar] [CrossRef] [PubMed]
- Wang, Y.M.; Guo, J.W.; Zhuang, J.P.; Jing, Y.B.; Shao, Z.K.; Jin, M.S.; Zhang, J.; Wei, D.Q.; Zhou, Y. Development and characterization of MAO bioactive ceramic coating grown on micro-patterned Ti6Al4V alloy surface. Appl. Surf. Sci. 2014, 299, 58–65. [Google Scholar] [CrossRef]
- Song, Y.; Shan, D.; Chen, R.; Han, E.-H. Corrosion characterization of Mg–8Li alloy in NaCl solution. Corros. Sci. 2009, 51, 1087–1094. [Google Scholar] [CrossRef]
- Cui, L.-Y.; Gao, S.-D.; Li, P.-P.; Zeng, R.-C.; Zhang, F.; Li, S.-Q.; Han, E.-H. Corrosion resistance of a self-healing micro-arc oxidation/polymethyltrimethoxysilane composite coating on magnesium alloy AZ31. Corros. Sci. 2017, 118, 84–95. [Google Scholar] [CrossRef]
- Zou, Y.-H.; Wang, J.; Cui, L.-Y.; Zeng, R.-C.; Wang, Q.-Z.; Han, Q.-H.; Qiu, J.; Chen, X.-B.; Chen, D.-C.; Guan, S.-K.; et al. Corrosion resistance and antibacterial activity of zinc-loaded montmorillonite coatings on biodegradable magnesium alloy AZ31. Acta Biomater. 2019, 98, 196–214. [Google Scholar] [CrossRef]
- Baghdadabad, D.M.; Baghdadabad, A.R.M.; Khoei, S.M.M. Characterization of bioactive ceramic coatings synthesized by plasma electrolyte oxidation on AZ31 magnesium alloy having different Na2SiO3·9H2O concentrations. Mater. Today Commun. 2020, 25, 101642. [Google Scholar] [CrossRef]
- Ko, Y.G.; Namgung, S.; Shin, D.H. Correlation between KOH concentration and surface properties of AZ91 magnesium alloy coated by plasma electrolytic oxidation. Surf. Coat. Technol. 2010, 205, 2525–2531. [Google Scholar] [CrossRef]
- Li, T.; Li, L.; Qi, J.; Chen, F. Corrosion protection of Ti6Al4V by a composite coating with a plasma electrolytic oxidation layer and sol-gel layer filled with graphene oxide. Prog. Org. Coat. 2020, 144, 105632. [Google Scholar] [CrossRef]
- Chen, Y.; Li, W.; Wang, W.; Zhao, Y.; Chen, M. Microstructure, corrosion resistance, and antibacterial properties of an Ag/Mg-Al layered double hydroxide coating synthesized in situ on biomedical Mg-Zn-Ca alloy. Ceram. Int. 2022, 48, 4172–4187. [Google Scholar] [CrossRef]
- Pathak, N.; Ghosh, P.S.; Gupta, S.K.; Kadam, R.M.; Aryab, A. Defects induced changes in the electronic structures of MgO and their correlation with the optical properties:a special case of electron–hole recombination from the conduction band. RCS Adv. 2016, 6, 96398. [Google Scholar]
- Han, D.; Han, Y.; Li, J.; Liu, X.; Yeung, K.W.K.; Zhen, Y.; Cui, Z.; Yang, X.; Liang, Y.; Li, Z.; et al. Enhanced photocatalytic activity and photo-thermal effects of cu-doped metal-organic frameworks for rapid treatment of bacteria-infected wounds. Appl. Catal. B Environ. 2020, 261, 118248. [Google Scholar] [CrossRef]
- Liu, L.; Huang, B.; Liu, X.; Yuan, W.; Zheng, Y.; Li, Z.; Yeung, K.W.K.; Zhu, S.; Liang, Y.; Cui, Z.; et al. Photo-controlled degradation of PLGA/Ti3C2 hybrid coating on Mg-Sr alloy using near infrared light. Bioact. Mater. 2021, 6, 568–578. [Google Scholar] [CrossRef]
- Nain, A.; Wei, S.; Lin, Y.; Tseng, Y.; Mandal, R.P.; Huang, Y.; Huang, C.; Tseng, F.; Chang, H. Copper Sulfide Nanoassemblies for Catalytic and Photoresponsive Eradication of Bacteria from Infected Wounds. ACS Appl. Mater. Interface 2021, 13, 7865–7878. [Google Scholar] [CrossRef]
- Ni, J.; Liu, D.; Wang, W.; Wang, A.; Jia, J.; Tian, J.; Xing, Z. Hierarchical defect-rich flower-like BiOBr/Ag nanoparticles/ultrathin g-C3N4 with transfer channels plasmonic Z-scheme heterojunction photocatalyst for accelerated visible-light-driven photo-thermal-photocatalytic oxytetracycline degradation. Chem. Eng. J. 2021, 419, 129969. [Google Scholar] [CrossRef]
- Ikonopisov, S. Theory of electrical breakdown during formation of barrier anodic films. Electrochim. Acta 1977, 22, 1077–1082. [Google Scholar] [CrossRef]
- Dou, J.; Wang, J.; Lu, Y.; Chen, C.; Yu, H.; Ma, R.L.-W. Bioactive MAO/CS composite coatings on Mg-Zn-Ca alloy for orthopedic applications. Prog. Org. Coat. 2021, 152, 106112. [Google Scholar] [CrossRef]
- Tan, J.; Wang, D.; Cao, H.; Qiao, Y.; Zhu, H.; Liu, X. Effect of Local Alkaline Microenvironment on the Behaviors of Bacteria and Osteogenic Cells. ACS Appl. Mater. Interface 2018, 10, 42018–42029. [Google Scholar] [CrossRef]

| Sample | Rs (ohm·cm2) | CPE1 (μF·cm−2) | n1 | R1 (ohm·cm2) | CPE2 (μF·cm−2) | n2 | R2 (ohm·cm2) | RL (ohm·cm2) | L (H·cm−2) |
|---|---|---|---|---|---|---|---|---|---|
| P1 | 51.42 | 2.88 × 10−5 | 0.68 | 111.80 | 2.99 × 10−5 | 0.80 | 416.10 | 323.60 | 3.68 × 103 |
| P2 | 36.24 | 3.36 × 10−5 | 0.66 | 111.90 | 2.62 × 10−5 | 0.81 | 574.10 | 494.80 | 8.59 × 103 |
| P3 | 51.41 | 3.57 × 10−5 | 0.62 | 218.50 | 2.90 × 10−5 | 0.78 | 2654.00 | 776.00 | 2.19 × 103 |
| P4 | 39.26 | 2.65 × 10−5 | 0.67 | 122.20 | 2.85 × 10−5 | 0.83 | 688.60 | 771.50 | 2.06 × 104 |
| Sample | Icorr (A/cm2) | Ecorr (V) | βa (mV) | −βc (mV) | Rp (Ω·cm2) |
|---|---|---|---|---|---|
| Mg alloy | 3.52 × 10−5 | −1.59 | 333.18 | 607.74 | 0.26 × 103 |
| P1 | 5.47 × 10−6 | −1.57 | 166.59 | 203.68 | 5.88 × 103 |
| P2 | 5.44 × 10−6 | −1.47 | 181.61 | 294.38 | 8.30 × 103 |
| P3 | 1.08 × 10−6 | −1.45 | 72.47 | 133.75 | 1.70 × 104 |
| P4 | 4.21 × 10−6 | −1.47 | 206.03 | 218.87 | 1.13 × 104 |
Publisher’s Note: MDPI stays neutral with regard to jurisdictional claims in published maps and institutional affiliations. |
© 2022 by the authors. Licensee MDPI, Basel, Switzerland. This article is an open access article distributed under the terms and conditions of the Creative Commons Attribution (CC BY) license (https://creativecommons.org/licenses/by/4.0/).
Share and Cite
Li, T.; Zhao, Y.; Chen, M. Study on Enhancing the Corrosion Resistance and Photo-Thermal Antibacterial Properties of the Micro-Arc Oxidation Coating Fabricated on Medical Magnesium Alloy. Int. J. Mol. Sci. 2022, 23, 10708. https://doi.org/10.3390/ijms231810708
Li T, Zhao Y, Chen M. Study on Enhancing the Corrosion Resistance and Photo-Thermal Antibacterial Properties of the Micro-Arc Oxidation Coating Fabricated on Medical Magnesium Alloy. International Journal of Molecular Sciences. 2022; 23(18):10708. https://doi.org/10.3390/ijms231810708
Chicago/Turabian StyleLi, Tianlu, Yun Zhao, and Minfang Chen. 2022. "Study on Enhancing the Corrosion Resistance and Photo-Thermal Antibacterial Properties of the Micro-Arc Oxidation Coating Fabricated on Medical Magnesium Alloy" International Journal of Molecular Sciences 23, no. 18: 10708. https://doi.org/10.3390/ijms231810708
APA StyleLi, T., Zhao, Y., & Chen, M. (2022). Study on Enhancing the Corrosion Resistance and Photo-Thermal Antibacterial Properties of the Micro-Arc Oxidation Coating Fabricated on Medical Magnesium Alloy. International Journal of Molecular Sciences, 23(18), 10708. https://doi.org/10.3390/ijms231810708
